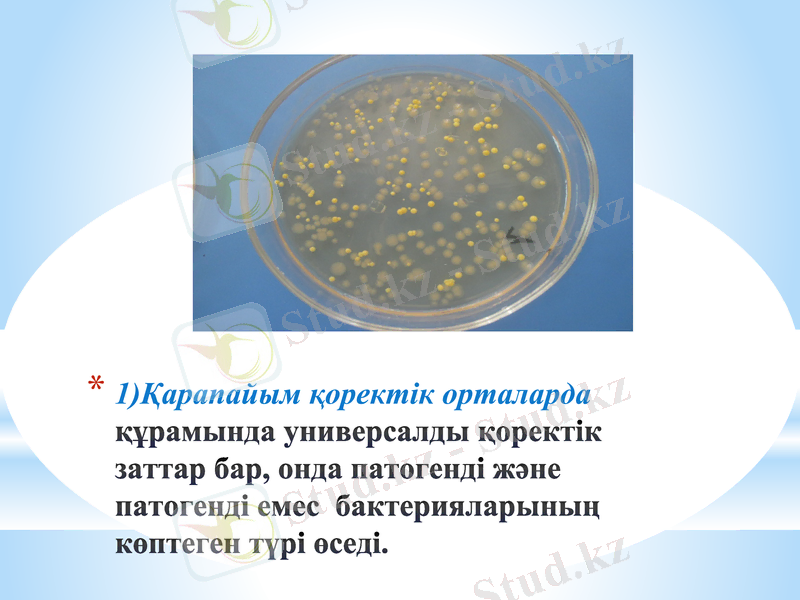
Slide 16
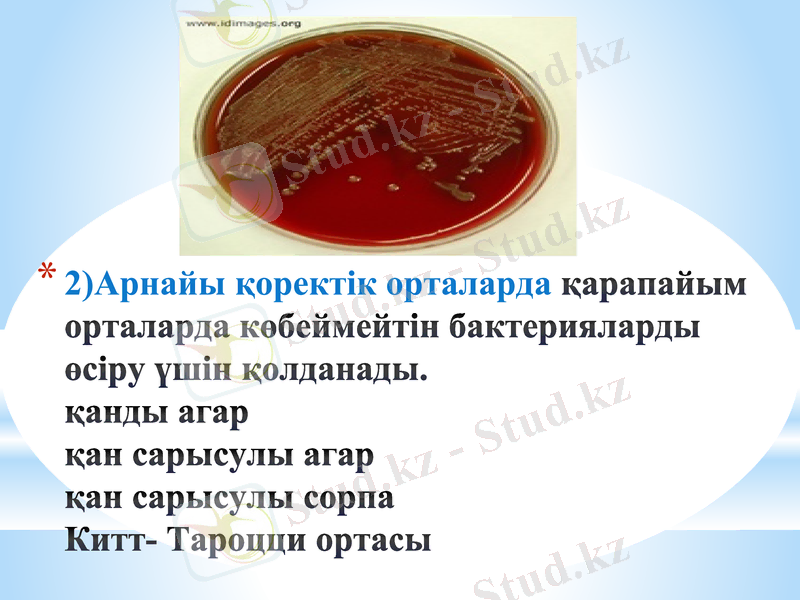
Slide 17

Микроорганизмдерді өсірудің негіздері: қоректену түрлері, энергия мен азот көздері және мәдени орталар



Микроорганизмдерді өсірудің негіздері
Орындаған :
Тексерген:

Көміртегін сіңіруіне қарай барлық микроорганизмдерді автотрофтар және гетеротрофтар деп бөледі:
Автотрофтар (литотрофтар) - органикалық көміртегіні мұқтаж емес олар көміртегін, ауадаға көмір қышқылынан кейбір минерал заттар тотыққанда бөлінетін энергияның көмегімен, яғни хемосинтез жолымен алады. Бір сөзбен айтқанда ауадағы CO2 көміртек көздері ретінде қолданады.
Гетеротрофтар( органотрофтар) - көміртегін дайын органикалық қосылыстардан алады, яғни көміртектің көзі ретінде органикалық заттарды қажет етеді.
көптеген шіріту бактериялары,
әр түрлі ашу процесін қоздырушылар,
түрлі ауыру тудырушы микроорганизмдер жатады.


1. Метатрофтар (сапрофиттер) өсімдіктердің және жануарлардың өлекселерімен қоректенеді, яғни көмір қышқылын осындай органикалық заттар ыдырағанда қамтиды.

2. Паратрофты микроорганизмдер тіршілігі үшін тірі белоктар қажет. Олар тірі организмде тіршіік етуге бейімделеген. Бұған адамдағы, жануарлар мен өсімдіктердегі түрлі ауру қоздырғыштар жатады.


1. Аминоавтотрофтылар -торша белок синтезі үшін ауадағы молекулярлы азотты немесе аммоний қабатын қолданады .

2. Аминогетеротрофтылар - азотты органикалық қосылыстардан- амин қышқылынан, күрделі белоктардан алады. Бұған барлық патогенді микроорганизмдер мен сапрофиттер жатады.

Энергия көзін пайдалануына қарай :
Фототрофтар - күн көзінің жарығын тұтынушы
2. Хемотрофтар - энергиялық материал ретінде әр түрлі органикалық және органикалық емес заттарды қолданады

Фототрофтар
Хемотрофтар
Фотолитроф-
тар
Фотооргано-
трофтар
Хемооргано-
гетеротрофтар
Хемолитоавто-
трофтар

Фототрофтар қоректену типі бойынша екіге бөлінеді:
Фотолитрофтар-көмір қышқыл газы (СО2) мен органикалық емес (Н2О, Н2S, S) қосылыстардан клеткаларына қажетті заттарды синтездеу үшін күн көзінің энергиясын қолданады, яғни жалпы фотосинтез арқылы қоректенетін микроорганизмдер.
цианобактериялар,
қошқыл күкірт бактериялары,
жасыл күкірт бактериялары жатады.

2. Фотоорганотрофтар- клеткаға қажетті заттарды синтездеу үшін энергияны тек фотосинтез құбылысы ғана емес, сонымен бірге жай органикалық қосылыстардан да алуға бейімделген.

Хемотрофтар қоректену бойынша типі екіге бөлінеді:
1. Хемолитоавтотрофтар- тіршілік ету үшін энергияны органикалық емес қосылыстарды (Н2, NO2, NH4, Fe, H2S, S, SO3, S2O3, CO) және тағы басқаларды тотықтыру барысында қамтиды. Бұл процесті хемосинтез деп атайды.
темір және нитрификциялаушы бактериялар жатады.

2. - энергия мен көміртегін органикалық қосылыстардан қамтиды. Бұған топырақта және басқа да субстраттарда тіршілік ететін көптеген аэробты және анаэробы микроорганизмдер жатады

1) Қарапайым қоректік орталарда құрамында универсалды қоректік заттар бар, онда патогенді және патогенді емес бактерияларының көптеген түрі өседі.
2) Арнайы қоректік орталарда қарапайым орталарда көбеймейтін бактерияларды өсіру үшін қолданады. қанды агар қан сарысулы агар қан сарысулы сорпа Китт- Тароцци ортасы

3) Қалаулы(элективті) арнайы бір микроб түрін бөлу үшін, өсуге қабілеттілігі бар, микроорганизмдермен бірге жүретін өсуге ұқсас орталар жатады. Өт қышқылының тұздары, ішек таяқшасының өсуіне ұқсас іш сүзегі үшін элективті орта жасайды.

4) Дифференциалды - диагностикалық орталар ферментативтік белсенділігі бойынша микробтың бір түрін басқалардан ажыратуға болады : Гисс ортасы Эндо ортасы висмут-сульфит ортасы
- Іс жүргізу
- Автоматтандыру, Техника
- Алғашқы әскери дайындық
- Астрономия
- Ауыл шаруашылығы
- Банк ісі
- Бизнесті бағалау
- Биология
- Бухгалтерлік іс
- Валеология
- Ветеринария
- География
- Геология, Геофизика, Геодезия
- Дін
- Ет, сүт, шарап өнімдері
- Жалпы тарих
- Жер кадастрі, Жылжымайтын мүлік
- Журналистика
- Информатика
- Кеден ісі
- Маркетинг
- Математика, Геометрия
- Медицина
- Мемлекеттік басқару
- Менеджмент
- Мұнай, Газ
- Мұрағат ісі
- Мәдениеттану
- ОБЖ (Основы безопасности жизнедеятельности)
- Педагогика
- Полиграфия
- Психология
- Салық
- Саясаттану
- Сақтандыру
- Сертификаттау, стандарттау
- Социология, Демография
- Спорт
- Статистика
- Тілтану, Филология
- Тарихи тұлғалар
- Тау-кен ісі
- Транспорт
- Туризм
- Физика
- Философия
- Халықаралық қатынастар
- Химия
- Экология, Қоршаған ортаны қорғау
- Экономика
- Экономикалық география
- Электротехника
- Қазақстан тарихы
- Қаржы
- Құрылыс
- Құқық, Криминалистика
- Әдебиет
- Өнер, музыка
- Өнеркәсіп, Өндіріс
Қазақ тілінде жазылған рефераттар, курстық жұмыстар, дипломдық жұмыстар бойынша біздің қор #1 болып табылады.



Ақпарат
Қосымша
Email: info@stud.kz